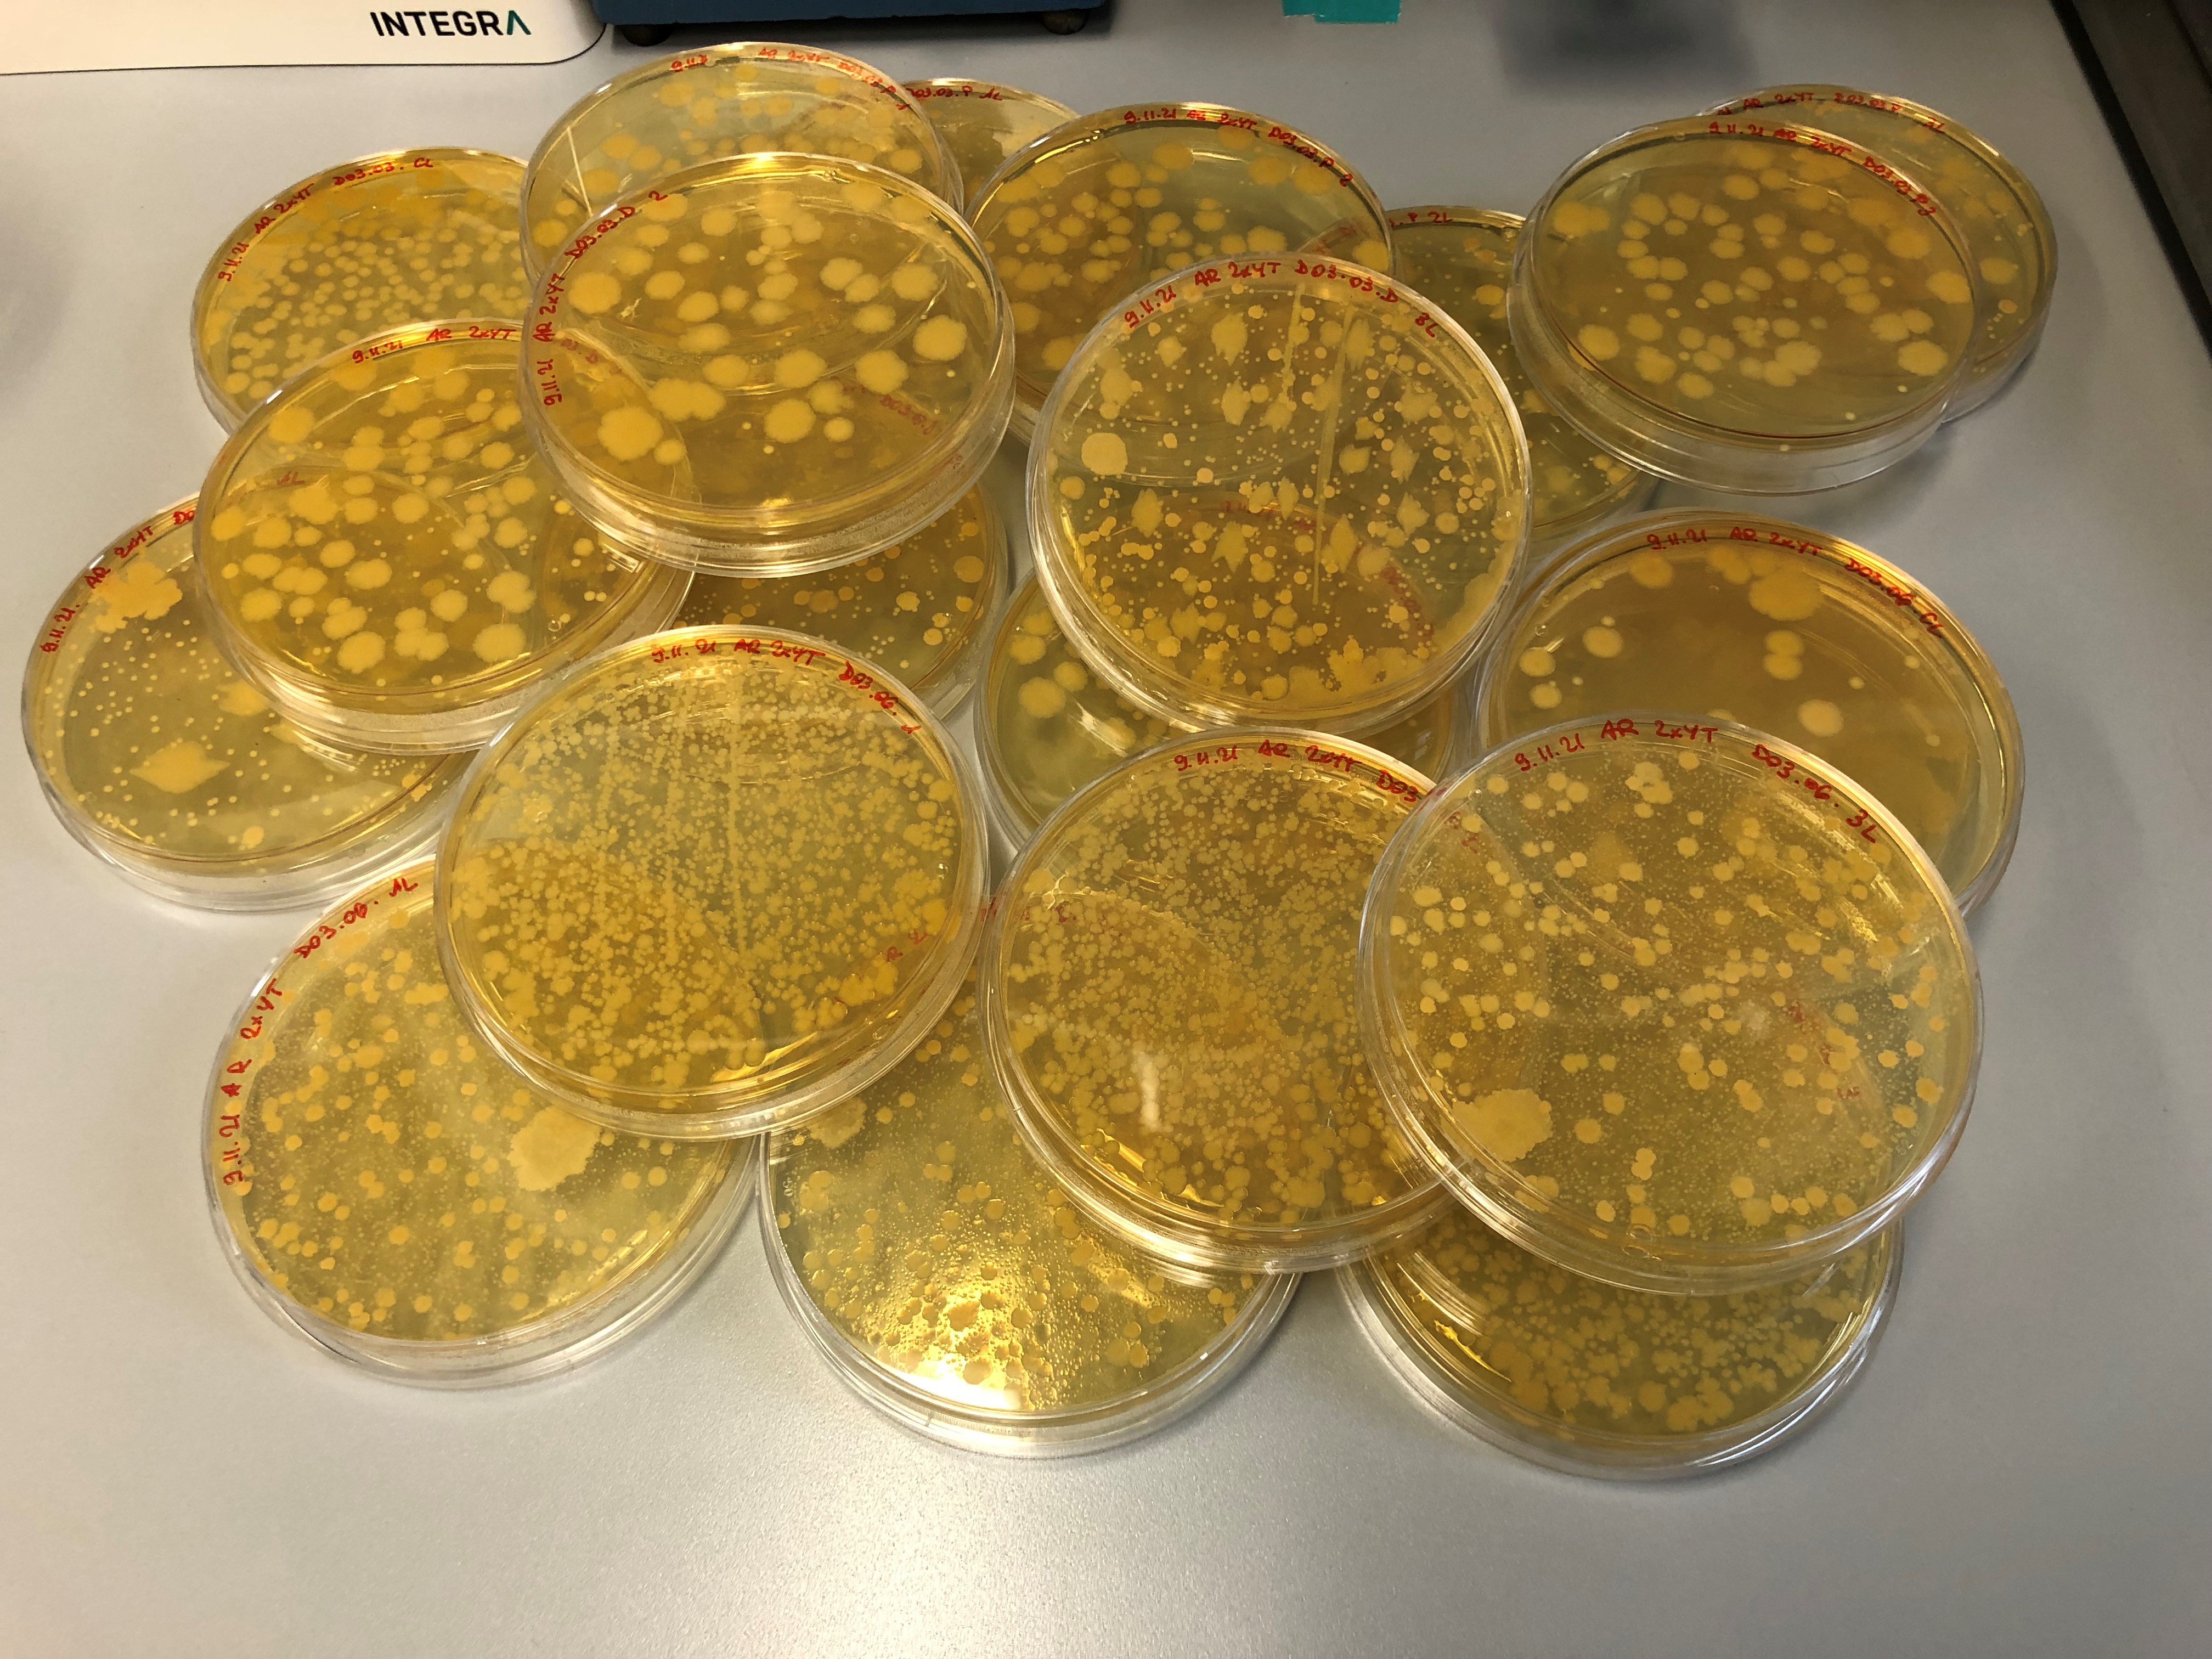

Research interests
Summary
Due to environmental or physiopathological factors, an imbalance in the number and/or diversity of the gut microbiota can occur. This phenomenon is called “dysbiosis”. In fact, studies have shown that dysbiosis can be related to Crohn’s disease, ulcerative colitis, irritable bowel syndrome, Clostridioides difficile infection (CDI), Alzheimer’s disease, depression or even cancer.
As novel applications of bacteriological entities are rising, the need for efficient formulations to deliver safely microorganisms to patients becomes of major importance. In this project, we aim to develop a robust gastro-resistant, enteric-targeted oral formulation with a complex mixture of bacteria. In parallel, we have a collaboration with the University Hospital of Lausanne (CHUV) to optimize the oral delivery of Fecal Microbiota Transplantation.
Key image

Perivascular formulation for the prevention of restenosis. The right dose at the right place
Research interests
Summary
After a bypass graft surgery, almost half of the patients will develop restenosis which is the renarrowing of the graft vessel. Current preventive treatments imply repetitive oral dosing of active compounds, with high risk of side effects. To avoid these limitations, we are developing a drug delivery system (DDS) to be applied during the surgical procedure directly to the anastomosis site. This DDS loaded with atorvastatin is based on hydrogels and PLGA microparticles, to achieve a local sustained release with a single administration.
Collaboration: Dr. Olivier Jordan, Biopharmacy lab, ISPSO
Dr. Francois Saucy, vascular surgery department, CHUV, Lausanne
Key image


Gadolinium-based micelles as new MRI contrast agent for intracranial aneurysm visualization
Research interests
Summary
Intracranial aneurysm (IA) is the result of the deformation and the enlargement of the arterial lumen that affect 2 – 3 % of the population. IA are mostly asymptomatic but are at risk of rupture which can induce a subarachnoid hemorrhage that could be fatal. To avoid such risk, the decision to clip or coil the aneurysm is often taken. Nonetheless these interventions are also hazardous so it is essential to only treat aneurysm at high risk of rupture. We search biomarkers of IA wall instability that could be used to synthetize a new Gadolinium-based micellar contrast agent. This targeted contrast agent will allow the discrimination of stable versus unstable aneurysm which will help in the decision to treat or not the aneurysm.

Formulation development and delivery strategies for sustained topical drug delivery with application to treat skin and nail disorders